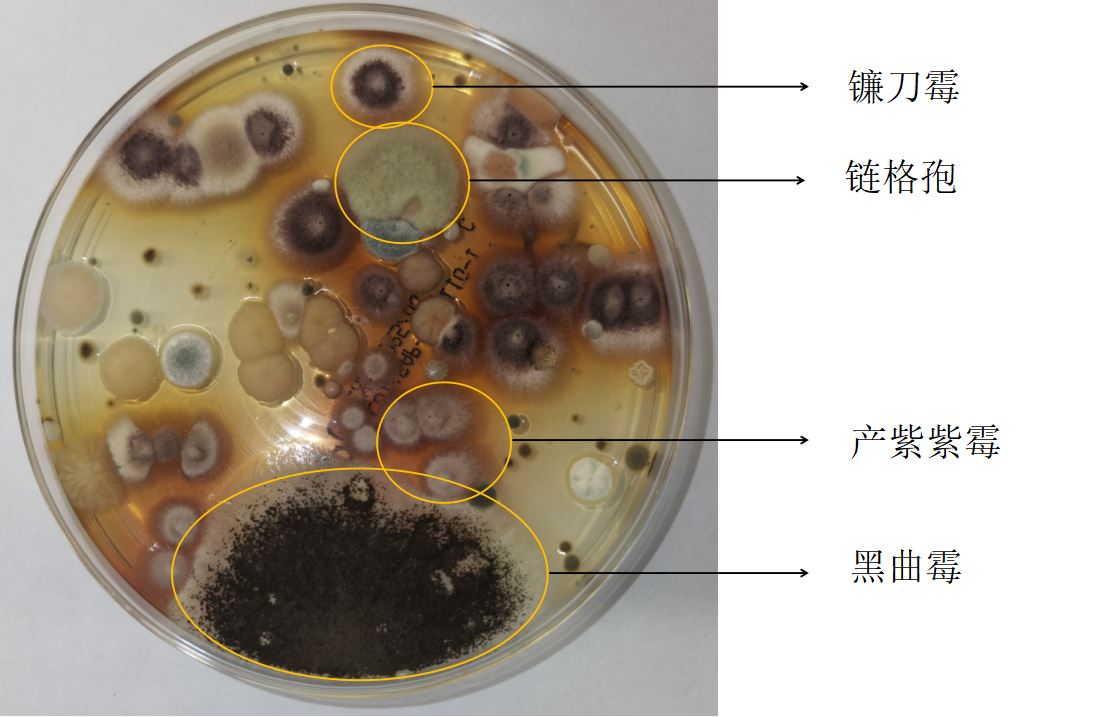
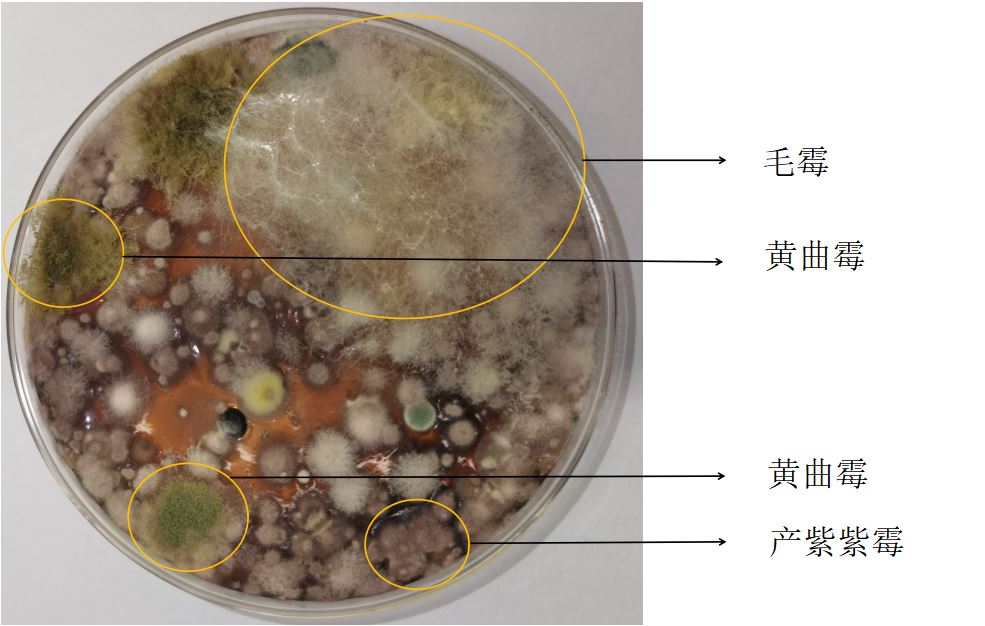
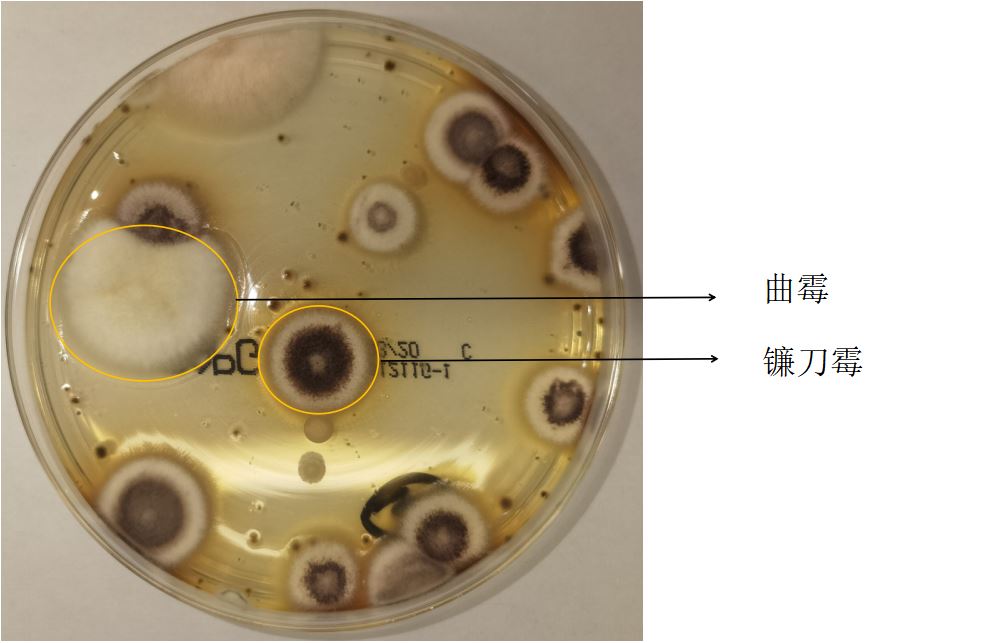
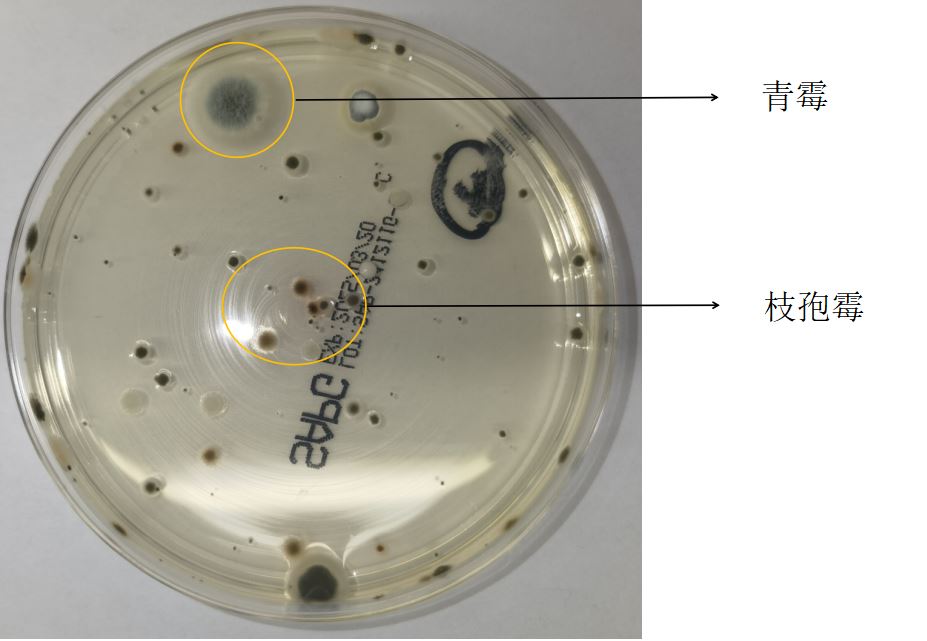
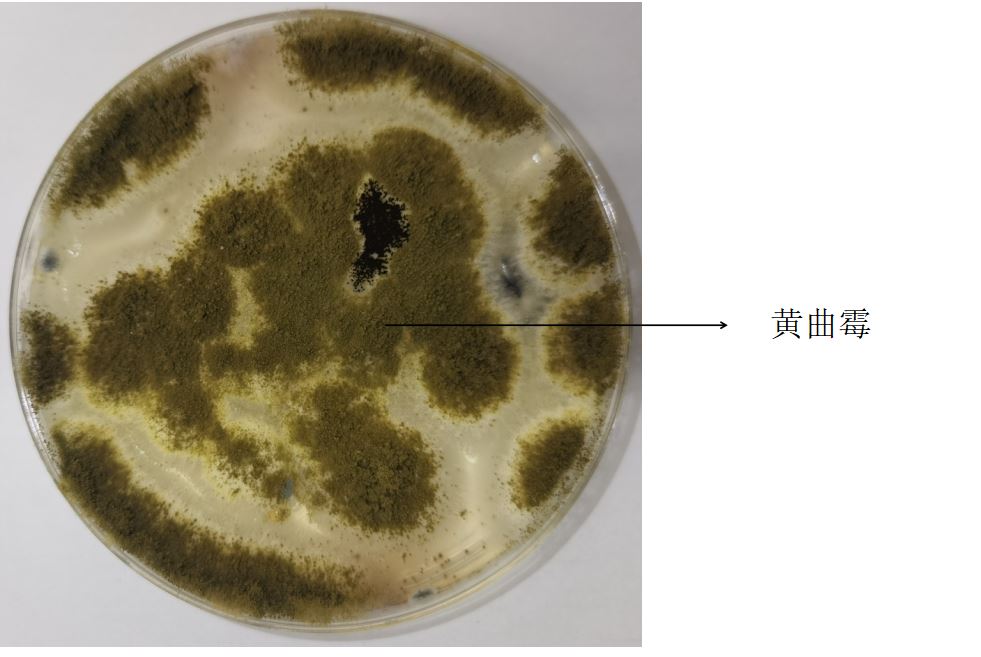
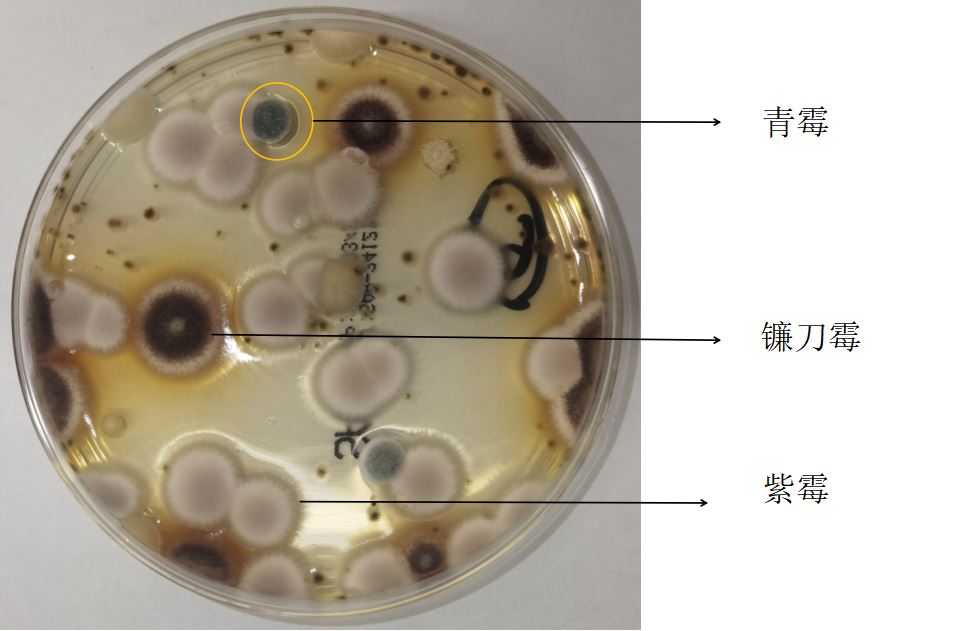

你是否注意到浴室角落的黑色斑点,瓷砖缝隙间的绿色绒毛,洗手台下的黄色印迹等这些看似不起眼的霉菌,其实都暗藏着健康隐患。
霉菌是自然界分布很广的一种微生物,存在于土壤、空气中。霉菌孢子在温湿度、氧气及营养物质适宜时迅速繁殖,并在环境中广泛存在。
影响霉菌生长的因素
湿度:室内相对湿度是影响霉菌生长的关键因素。根据研究,霉菌生长的最适相对湿度一般为75%~95%。
温度:霉菌菌丝体生长温度范围为15~30℃。
营养物质:室内垃圾、灰尘等为霉菌的生长提供有利条件。
太阳辐射:太阳辐射中的各种射线能杀死霉菌。综上所述,浴室堪称霉菌生长的“乐园”。

实验过程及结果试验方法:于浴室中取六个常见污染点位,用沙氏培养基于27℃恒温培养3×24小时后取出。通过菌落形态和镜下观察判断菌种。
1号地漏
2号墙根
3号清洁过的地漏
4号水龙头周围
5号墙砖缝隙
6号马桶美缝胶
显微镜下形态图:


呼吸道疾病:霉菌孢子被人体吸入后,可能引发过敏(过敏性鼻炎)、哮喘、肺炎等呼吸道疾病。皮肤:会导致皮肤瘙痒、红肿、脱皮等症状,严重时甚至引发皮肤病。免疫力下降:长期接触霉菌,会削弱人体免疫力,使人更容易生病,并引发一系列过敏反应。但也请不必过度焦虑,正常人的免疫系统足以应付这些环境霉菌,若是结构性肺病、结核感染、糖尿病患者、长期服用糖皮质激素药物等免疫力低下人群,可能造成机会感染。防治方法日常清洁:每次沐浴后,务必清理浴室地砖、墙砖等霉菌易生区域,一旦发现黑色、绿色或褐色斑点乃至绒毛状霉菌,应立即彻底清除。定期消毒:使用稀释的漂白水或专门的霉菌清洁剂,定期清洁浴室,特别是角落和缝隙。湿度管控:沐浴结束后,开启排气扇或窗户,确保浴室空气流通,维持干燥环境。加强通风:增加排风通风装置,对进排风口设置防回潮措施,避免风口处冷凝结露,如有可能在浴室增设窗户。更换老旧设施:及时更换老旧浴帘、地垫等。使用防霉产品:可以选择防霉涂料、防霉胶水等产品,预防霉菌滋生。浴室霉菌,看似微不足道,却可能对我们的健康造成威胁。请注意:如果出现疑似霉菌感染的症状,请及时就医,并告知医生可能的霉菌接触史。
参考文献:[1]路冰洁,杜晨秋,郭芯竹,等.温湿度对建筑室内典型霉菌生长影响及其动力学模型[J].中国环境科学,2023,43(03):1368-1377.[2]郑志敏,罗慧,文韬,等.建筑室内霉菌生长与防治方法研究[J].制冷,2023, 42(01):35-42.[3]王雪妃,田玉洁.慢性阻塞性肺疾病合并呼吸系统曲霉菌感染研究进展[J].中华医院感染学杂志,2022,32(24):3822-3826.[4]刘晓宇,李钊,陈剑波.建筑室内环境霉菌生长影响因素与控制分析[J].能源与环境,2019,(03):71-72+74.

北京清华长庚医院APP
快速挂号